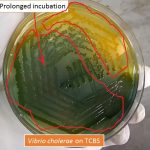
Vibrio cholerae on TCBS agar after prolonged incubation

Collection Group: Clinical Bacteriology
Motility of Bacteria: Principle, Procedure and Examination
 Motility of Bacteria Motility of bacteria as shown above picture....
Motility of Bacteria Motility of bacteria as shown above picture....
Ideal Sputum Specimen: Introduction, Selection and Rejection Criteria
 Introduction of Ideal Sputum Specimen Prior to culturing a sputum specimen,...
Introduction of Ideal Sputum Specimen Prior to culturing a sputum specimen,...
Vibrio cholerae on TCBS Agar after Prolonged Incubation and Its Details
Vibrio cholerae on TCBS Agar After Prolonged Incubation Vibrio cholerae...
Vibrio cholerae on TCBS Agar After Prolonged Incubation Vibrio cholerae...
